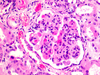

(P2) Dis of Imm: Lupus nephritis (357) Flashcards
- name this slide*
- Looking at the upper right Glomeruli-*
name and define the cells inside

Lupus nephritis
Mesangial cells are specialised cells in the kidney that make up the mesangium of the glomerulus.
-Mesangial cells can contract and relax to regulate capillary flow. This is regulated by vasoactive substances.
They are specialized smooth muscle cells that function to regulate blood flow through the capillaries.
Usually divided in to 2 types, each having a very distinct function and location. Extraglomerular & intraglomerular mesangial cells
Lupus nephritis
Inside the Glomeruli, the MESENGLIAL CELLS are undergoing what type of action?

Diffuse or Focal proliferation
of
mesangial cells
in glomeruli
Lupus Nephritis
- Describe the histological*
- characteristics:*
- Narrow lumen of capillaries within the glomeruli*
- Proliferation of cells (hypercellular pattern)*
- Delicate, homogenous thickening of capillary wall (wire-loop lesion) Sub-endothelial deposits*
- Wire-loop leasion (thickening of capillary)*
- 5. Subendothelial deposits (between endothelium and basement memebrane) of immune complexes*
- Thickened, hyalinized loops of capillaries*
- Usually in class IV (also in III and V)*
- Indicates active disease*
Lupus nephritis
- What disease is this commonly associated with?
- What parts of the body does it affect?

1. SLE (Systemic Lupus Erythematosus)
2. kidneys,
joints,
serious membrane,
skin
Name 2 diagnostic markers of
Lupus nephritis
- Smith antigen – soluble nuclear antigen complex that is part of spliceosome*
- Antibody to double stranded DNA*
What type of cells are proliferated in Lupus nephritis
and
what deposits are present?
Mesangial cells proliferate
and
deposits of IgG, IgM, IgE, IgC
systemic lupus erythematosus
S/S
Name all that apply
Symptoms
- Butterfly rash, pleural effusion, heart problems, lupus nephritis, arthritis, Raynaud’s phenomenon
- Normal (only biochemical changes) no visible morphological change
Mesangial – proliferation of mesangium, mesangial matrix, deposits of IgG, IgM, IgE
and C
5 patterns of SLE glomerular injury
1. Minimal or none (rare)
2. Mesangial lupus glomerulonephritis
a. Mesangial proliferation
b. Mesangial matrix, deposits of IgG, IgM, IgE and Complement
3. Focal proliferative glomerulonephritis
a. Only portions of each glomerulus affected
4. Diffuse proliferative glomerulonephritis
a. Proliferation of endothelial, mesangial, sometimes epithelia cells
b. Most serious. All glomeruli affected
5. Membranous glomerulonephritis
a. Widespread thickening of capillary walls
Raynaud’s phenomenon
define:
Raynaud’s phenomenon is a condition that can cause discomfort as the blood supply to your extremities becomes reduced.
In general, fingers and toes are affected, but other parts of your body such as your nose, lips and ears can be affected too.

SLE
Define:
systemic lupus erythematosus
is the most common type of lupus.
SLE is an autoimmune disease in which the immune system attacks its own tissues, causing widespread inflammation and tissue damage in the affected organs
Systemic lupus erythematosus (SLE)
- Is conidered what type of disease:*
- Can affect what body parts:*
- “Systemic Autoimmune Disease”*
- It can affect the joints, skin, brain, lungs, kidneys, and blood vessels,*
- There is no cure for lupus*



